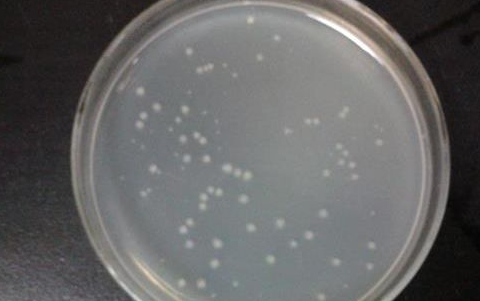

牛肉膏和蛋白胨主要为微生物提供什么营养物质
牛肉膏为微生物提供碳源、磷酸盐和维生素,蛋白胨主要提供氮源和维生素,NaCl提供无机盐。
方法:在烧杯内加水100毫升,放入牛肉膏、蛋白胨和氯化序遮缕塑钠,用蜡笔在烧杯外作上记号后,放在火上加热。待烧杯内各组分溶解后,加入琼脂,不断搅拌以免粘底。等琼脂完全溶解后补足失水,用10%盐酸或10%的氢氧化钠调整pH值到7.2~7.6,分装在各个试管里,加棉花塞,用高压蒸汽灭菌:1.05千克每平方厘米、121摄氏度维持15~30分钟。
扩展资料:
培养基物理分类
1、液体培养基
80%~90%是水,其中配有可溶性的或不溶性的营养成分的培养基。
2、固体培养基
一类配制成的固体状态的基质。根据性质又分为固化培养基、非可逆性固化培养基、天然固态培养基、滤膜。
3、半固体培养基
指在液体培养基中加入少量的凝固剂而配制成的半固体状态的培养基。
4、脱水培养基
又称预制干燥培养基,指含有除水分外的一切成分的商品培养基。
参考资料:百度百科-牛肉膏蛋白胨琼脂培养基